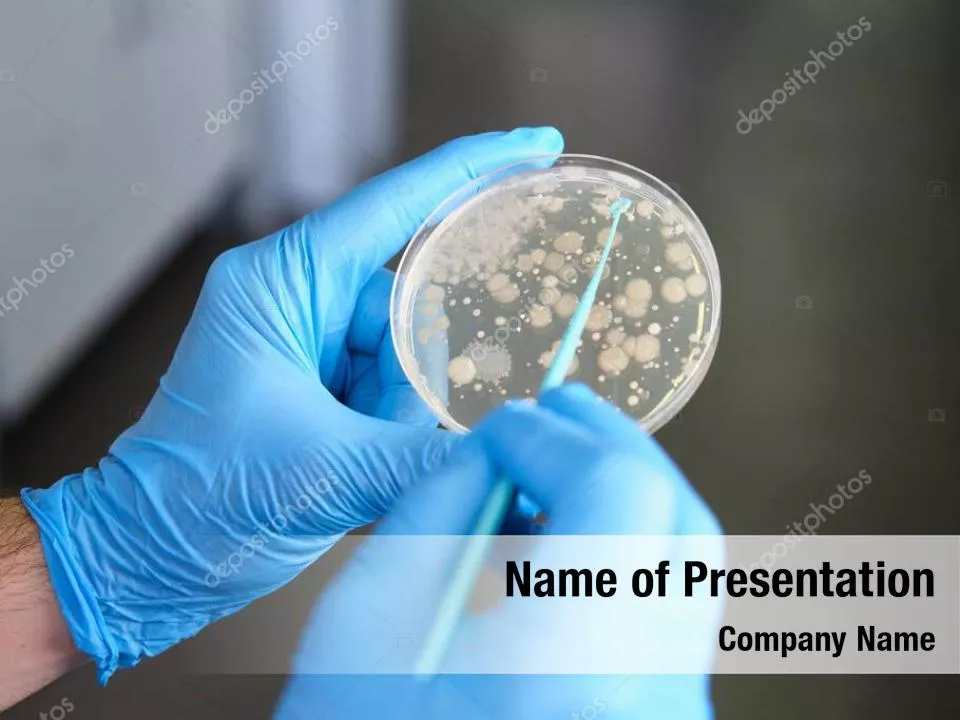
Microbiology
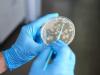

Add dynamic action to your work with this fully editable and professional Microbiology PowerPoint Template to complete all your reports and personal or professional presentations. This template will be a great choice for templates on plate, medicine, dish, hands, gloves, Bacterial, biological etc. Download this stylish Microbiology PowerPoint Template Background instantly after purchase and enhance your productivity.
- Instant download on purchase
- PowerPoint Template Layout
- 18/7 Template Support
- Available in .POT file format
- Print Version template included
- Secure Online Checkout Process
- Thousands of Satisfied Customers
- Higher Resolutions HD Templates
Tags
PowerPoint Backgrounds
Boost your PowerPoint Presentations with the Microbiology theme. Our Microbiology PowerPoint Templates and Microbiology PowerPoint Backgrounds are pre-designed intelligently-built Royalty Free PowerPoint presentation templates used for creating stunning and amazing presentations and reports.
Our powerful templates are fully customizable to edit it according to your design requirements. Come back to download tons of visually stunning contemporary designs. Sizzle at your next presentation with these eye-catching PowerPoint Templates! Add your message or ideas to the pre-made PowerPoint Template and you're ready to rock at the work place. Uplift your presentation backgrounds to the next level with our power-packed and classy collections of PowerPoint Templates. Start creating professional and superior PowerPoint presentations with DigitalOfficePro PowerPoint Templates.
Subscribe & Save
Unlock this template and gain unlimited access to over one million templates.
Get this PowerPoint Template
- Master, Title and Print Slides
- 32 Editable Diagrams & Charts
- 27 PowerPoint Shapes
- Social Icon Set
- 20 Smart Diagrams
- Master, Title and Print Slides
- 32 Editable Diagrams & Charts
- 27 PowerPoint Shapes
- Social Icon Set
- 20 Smart Diagrams
- Master, Title and Print Slides
- 32 Editable Diagrams & Charts
- 27 PowerPoint Shapes
- Social Icon Set
- 20 Smart Diagrams


Unlimited Access to:
- PowerPoint Templates
- Video Background Templates
- Diagram Slides
- Map Slides
20 Download Credits
Unlimited Access to:
- PowerPoint Templates
- Video Background Templates
- Diagram Slides
- Map Slides
50 Download Credits
Unlimited Access to:
- PowerPoint Templates
- Video Background Templates
- Diagram Slides
- Map Slides
100 Download Credits
Compatible with
Download type
FILE SIZE
File Type